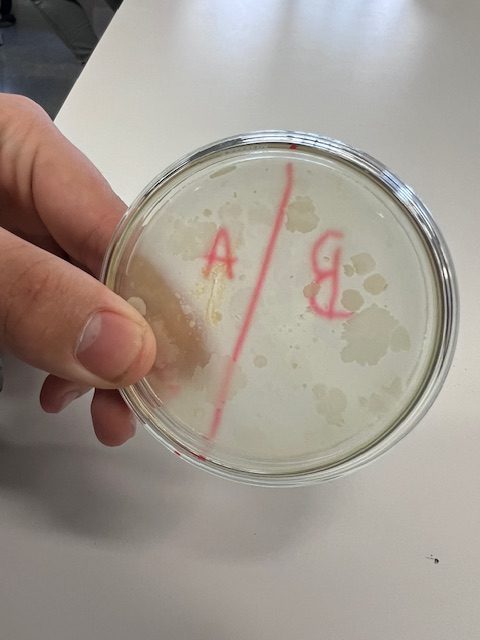

Los chicos y chicas del Slow Bar van a tope con la apertura de su servicio semanal. Todos los jueves, los y las profesionales del Burgos tienen el privilegio de poder ir a degustar el almuerzo preparado por el alumnado que cursa el programa. Bajo las órdenes de Esther y supervisados por Jorge, este gran equipo se pone manos a la obra para abrir su bar con mucha alegría y esfuerzo.
Esta apertura requiere de una gran organización y preparación. Toman nota de las comandas, van a comprar, preparan las recetas y arreglan el bar para recibir a sus comensales. Están poniendo todo de su parte. Aquí os compartimos algunas fotos, tanto de los productos que ofrecen como de ellos y ellas trabajando, para que veáis que en este Programa de Cualificación Básica están poniendo todo de su parte para aprender lo máximo posible. Todo tiene una pinta exquisita y se puede ver mucho amor en sus elaboraciones. Tienen lista de espera para probar sus degustaciones.
¡Enhorabuena a todos y a todas!